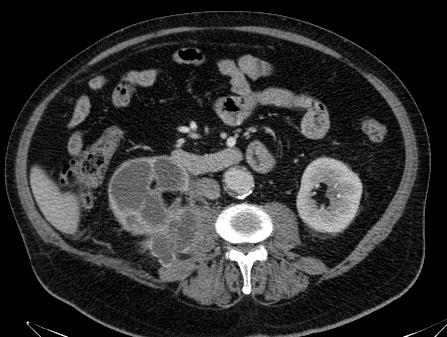
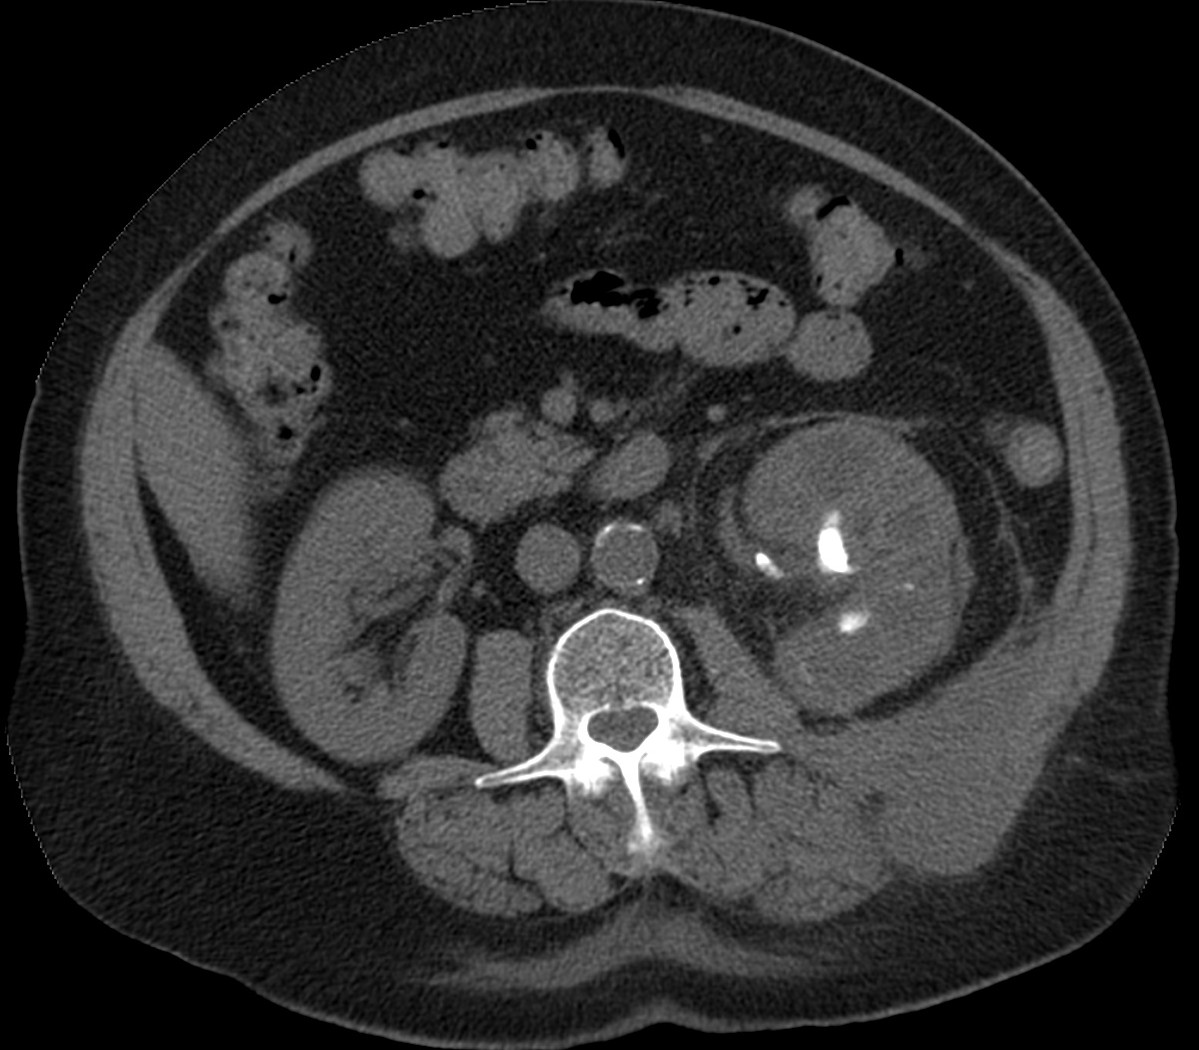

CASO 1: Paciente de 58 años que se realiza TC de abdomen tras historia de dolor abdominal y hematuria microscópica. Refiere pérdida de peso en las últimas semanas.





Estamos ante una afectación bilateral del espacio perirrenal, más evidente en el lado derecho, por masas de densidad de partes blandas en un paciente con numerosas adenopatías retroperitoneales. Estaría indicado realizar una biopsia, ya que el diagnóstico principal orienta hacia un síndrome linfoproliferativo, espcialmente linfoma no Hodgkin tipo B.
CASO 2: Paciente de 68 años con dolor en flanco izquierdo, fiebre y malestar general. A la exploración existe enrojecimiento de la piel con sensación de masa palpable y puño percusión muy positiva.



El paciente es alégrico al Iodo. Se realiza TC sin contraste para ampliar estudio.




Todos estos hallazgos están en relación con una Pielonefritis Xantunogranulomatosa que afecta al riñón derecho junto con una colección que ha fistulizado a región lumbar.
ESPACIO PERIRRENAL (EPR).
DESCRIPCIÓN.
El espacio perirrenal (EPR) es un espacio par, situado a cada lado de la columna, en el retroperitoneo.


Límite anterior: fascia renal anterior – o fascia de Gerota-, que lo separa del espacio pararrenal anterior.
Límite posterior: fascia renal posterior – o de Zuckerland-, que lo separa del espacio pararrenal posterior.
Límite superior: fascia renal posterior se fusiona con la porción posterolateral del diafragma y, en el lado derecho, se une al ligamento coronario inferior. La fascia renal anterior asciende hasta el diafragma sin llegar a cubrir el riñón y la suprarrenal, por lo que el espacio queda abierto al área desnuda del hígado, al diafragma y al mediastino, a través de los forámenes principales y accesorios.
Límite inferior, se fusionan las fascias perirrenales con la fascia ilíaca y el tejido conectivo periureteral, creando una barrera multilaminar que impide la comunicación del EPR con la pelvis.
Medialmente: ambos espacios se unen al nivel de los hilios renales y por debajo de éstos (entre L3 y L5), pero no por encima. Las fascias renales anterior y posterior se unen al denso tejido conectivo que rodea los grandes vasos.
Lateralmente: las fascias renal anterior y posterior se fusionan formando la fascia lateroconal.
CONTENIDO.
Cada EPR contiene:
- Riñón.
- Glándula suprarrenal.
- Porción superior del sistema colector.
- Vasos renales, red vascular perirrenal y red linfática.
- Grasa.
- Septos fibrosos (unen el riñón a las fascias y pueden actuar de barrera en la diseminación de procesos).
PATOLOGIA DEL EPR.
A- Procesos inflamatorios, colecciones.
- Infección.
- Urinoma.
- Sudor perirrenal.
- Hematoma.
B- Procesos sólidos.
- Carcinoma de células renales.
- Linfoma.
- Metástasis.
- Fibrosis.
- Pseudotumor diafragmático.
- Linfagiectasia.
C- Otros procesos.
A- PROCESOS INFLAMATORIOS, COLECCIONES.
1. INFECCIÓN.
La mayoría de los procesos infecciosos del EPR proceden del riñón. Si la infección rompe la cápsula renal, el EPR puede estar afectado de manera focal o difusa.
Se pueden observar signos como:
- Signos generales de inflamación.
- Engrosamiento de los septos perirrenales o fascia pararrenal. Gas localizado o difuso. Edema intersticial. Extensión a otras localizaciones: espacios pararrenales, tórax… . El engrosamiento de los septos del EPR se ve en múltiples patologías: inflamatorias (pielonefritis, absceso, pancreatitis), en hematomas y también en cuadros de obstrucción de la vía excretora. La imagen se ha descrito como «telaraña perirrenal». Es frecuente en pacientes mayores, encontrar engrosamientos septales aislados, sin significado patológico.
- Colecciones o abscesos.
- Puede ser secundario a infección renal extendida al EPR o sobreinfección de un urinoma o un hematoma.
- Factores de riesgo: inmunocomprometidos, diabetes.
- Clínica: fiebre, escalofríos, dolor abdominal o en flanco, cuadro séptico franco. Normalmente cursa con leucocitosis, bacteriuria y/o piuria.
- TC: masa bien delimitada, encapsulada, con contenido líquido denso y pared que se realza con contraste. Puede existir gas. Alrededor se ven septos engrosados y aumento de la densidad de la grasa perirrenal.
Fuente: Dr. Eugenio L. Navarro Sanchís. Unidad de Radiología de Urgencias. HRU de Málaga.
- Pielonefritis Xantunogranulomatosa.
- Es una forma infrecuente de pielonefritis crónica, de origen obstructivo, caracterizada por la formación de un absceso granulomatoso que puede extenderse al EPR-, severa destrucción renal y un cuadro clínico de fiebre, malestar general, dolor en el flanco y masa renal, a veces palpable.
- En placa simple podía verse un masa que renal con o sin borramiento de la línea del psoas. En ecografía, cálculos y aumento del tamaño renal en la forma difusa con múltiples áreas anecoicas correspondientes a las colecciones purulentas.
- Los hallazgos en TC pueden ser:
- Uni o bilateralidad de la lesión.
- Afección difusa o localizado.
- Litiasis de tipo coraliforme, calcificaciones intraparenquimatosas.
- Aumento difuso del tamaño renal.
- Áreas hipodensas o hipoecogénicas dentro de la lesión renal debidas a cálices dilatados, abscesos o áreas de necrosis parenquimatosa.
- Pobre o nula eliminación del medio de contraste en el riñón afectado.
- Compromiso inflamatorio que excede los límites del riñón y genera colecciones periféricas o extensión hacia vísceras vecinas.
2. URINOMA.
Colección de orina extravasada al EPR y más allá que puede ser debida a obstrucción, espontanea o iatrogenia (accidente quirúrgico). La orina causa una una lipolisis de la grasa adyacente que posteriormente forma un saco fibroso que da origen al urinoma.
En la TC ve como:
- Colección homogénea de atenuación líquida.
- Forma irregular de distribución peripiélica o periureteral cuando la perforación es a este nivel.
- Engrosamiento septal y de la fascia perirrenal.
- Si son crónicos, los urinomas con el tiempo pueden descender siguiendo los límites del EPR y pueden presentan cápsula fibrosa que se realza con contraste en el TAC y que rodea al riñóm, simulando una nefromegalia.

Fuente: Dr. Eugenio L. Navarro Sanchís. Unidad de Radiología de Urgencias. HRU de Málaga.
3. «SUDOR» PERIRRENAL.
Pequeñas cantidades de líquido perirrenal se presentan en cuadros de insuficiencia renal aguda o en casos de sobrecarga hídrica y edema generalizado.

4. HEMATOMA.
Puede ser debido a diferentes procesos:
- Traumático: lo más frecuentes son por accidentes de tráfico.
- Iatrogénico: biopsia renal, litotricia.
- Espontáneo: lo más frecuente es que sean debido a carcinoma renal, ruptura de angiomiolipoma. Otras causas son la malformación vascular renal (aneurisma arteria renal, MAV), ruptura de aneurisma de aorta abdominal, infarto capsular, arteritis, enfermedad renal avanzada, ruptura de quistes, trastornos hematológicos.
Los hallazgos incluyen una colección densa, irregular, reticulada o confluente en el EPR. En la fase aguda y subaguda puede detectarse un aumento de atenuación debido a la sangre y tras la administración de contrate puede verse el extravasado del mismo al EPR.
Si el sangrado es debido a un carcinoma, la masa sólida puede no ser evidente. Si se detecta densidad grasa en el interior de una masa que ha sangrado, la causa de dicha hemorragia es un angiomiolipoma, lo cual es importante remarcar para evitar más estudios o incurrir en una nefrectomía innecesaria.
Los hematomas pueden seguir el recorrido de los septos perirrenales, produciendo un patrón lineal en el EPR. Tarmbién, la conexión existente entre al área desnuda del hígado y el EPR se hace evidente en traumatismos donde se existen laceraciones hepáticas o sangrados esplénicos que mediante los septos llegan al EPR sin que exista un evidente traumatismo en el riñón o su vaculatura.
Un hematoma subcapsular se puede diferenciar de un hematoma perirrenal ya que el subcapsular produce una imagen lenticular o lineal a lo largo del margen renal, mientras que el perirrenal produce una forma excrecente a lo largo del margen renal. Puede ser difícil diferenciarlos cuando un hematoma perirrenal queda confinado por el septo reno-renal posterior que lo confina y le da una forma subcapsular.

Fuente: Dr. Eugenio L. Navarro Sanchís. Unidad de Radiología de Urgencias. HRU de Málaga.

5. LINFANGIECTASIA PERIRRENAL.
Anomalía benigna rara. Parece debida a obstrucción de los conductos linfáticos perirrenales.
Clínica: inespecífica.
Imagen: se caracteriza por la formación de quistes uni o multiloculares de pared fina en el EPR, por lo que puede confundirse con enfermedad quística renal. El diagnóstico puede hacerse por TAC y ecografía, y se confirma con la aspiración de linfa.

Fuente: Dr. Eugenio L. Navarro Sanchís. Unidad de Radiología de Urgencias. HRU de Málaga.
B- PROCESOS SÓLIDOS.
1. CARCINOMA DE CÉLULAS RENALES (CCR). (clíck para ver más)
Puede tener un crecimiento hacia la periferia, con invasión y rotura de la cápsula renal e infiltración del EPR, cuyo diagnóstico no siempre en posible con TC o RM. El tumor puede producir engrosamiento de la fascia perirrenal y de los septos, y espiculación en la grasa perirrenal. El tumor también puede extenderse como un bloque sólido en cualquier dirección sin afectar los septos del EPR.
Recordar que si en el seno de una masa encontramos densidad grasa, estamos ante un angiomiolipoma renal y no serían necesarios más estudios ni procedimiento invasivos como una nefrectomía.
Nota: Otros tumores que pueden afectar el EPR son los sarcomas, mielomas, mielolipomas.

2. LINFOMA.
El linfoma renal presenta una gran variedad de manifestaciones. Entre un 3 y un 8 % de linfomas estudiados por TAC tienen afectación renal o perirrenal, más frecuentemente el tipo no Hodgkin.
Patrones de afectación del linfoma renal:
- Multiples masas renales en el riñón (+frecuente)
- Lesión solitaria.
- Adenopatías retroperitoneales con extensión directa a riñón y EPR (nuestro caso de hoy).
- Afectación del espacio perirrenal aislada.
- Infiltración difusa de uno o ambos riñones.
En el caso de que el linfoma afecte al EPR, se ve como una masa homogénea que ocupa este espacio y que desplaza el riñón hacia adelante, ocupando a menudo también el espacio pararrenal anterior. La afectación aislada del EPR por el linfoma es poco frecuente (<10%), es más común la extensión directa desde las adenopatías o grandes conglomerados/masas retroperitoneales (+frec) o la extensión desde el riñón.


3. METÁSTASIS.
Las más frecuente son por melanoma, carcinoma renal y carcinoma de pulmón.
Pueden asentar en el EPR dada su rica red vascular y linfática, frecuentemente sin afectación renal simultánea. El tumor primario renal puede tener una diseminación hacia el EPR por vía linfática o por los vasos capsulares renales.
Imagen en TC: nódulos de tamaño y densidad variables, con o sin contacto con el riñón.

4. FIBROSIS.
Es un proceso inflamatorio y fibrótico que suele afectar el retroperitoneo central, afectando la aorta y la cava por delante. Es de localización infrarrenal, suele empezar por debajo de la bifurcación aórtica y desde ahí asciende. Secundariamente, puede englobar los uréteres pudiendo ocasionar hidroureteronefrosis. Se diferencia del linfoma en que NO produce desplazamiento anterior de la aorta.
Sin embargo, ocasionalmente puede extenderse más lejos y más lateral, afectando el espacio perirrenal. Hay una forma de fibrosis perirrenal que envuelve ambos riñones y se manifiesta como una banda densa alrededor de éstos que puede simular un linfoma.
Imagen en TC: Tejido con densidad de partes blandas, irregular y confluente, que en el caso de afectación del EPR puede rodear los riñones.
Imagen en RM: Hipointenso en T2. Sin embargo tambien puede ser hiperintenso si hay gran actividad inflamatoria. Si existe hipointensidad en T2, el diagnóstico de fibrosis ha de ser considerado.

5. SEUDOTUMOR DIAFRAGMÁTICO.
Inserciones diafragmáticas engrosadas cruzan el espacio perirrenal simulando una banda o un nódulo. Pueden reconocerse por su trayecto lineal, y a veces son necesarias reconstrucciones multiplanares. Constituyen una variante de la normalidad.

C- OTROS PROCESOS.
1. HEMATOPOYESIS EXTRAMEDULAR
Consiste en la presencia de elementos hematopoyéticos fuera de la médula ósea, como mecanismo compensador en enfermedades hematológicas. Se manifiesta como una masa de partes blandas bien delimitada de densidad homogénea similar a la del bazo.
2. AMILOIDOSIS.
Enfermedad por depósito de proteinas. Puede ser primaria o secundaria a varios trastornos, como la artritis reumatoide y el mieloma múltiple. Los depositos pueden darse en tracto gastrointestinal, riñones, hígado, bazo, pulmón o hueso. En ocasiones se deposita en el espacio perirrenal, infiltrando difusamente la grasa pero sin afectar al riñón. Se ven como colecciones inespecíficas de densidad tejido blando.
3. PANCREATITIS.
El líquido procedente del espacio pararrenal anterior puede extenderse al perirrenal bien formando colecciones o bien provocando engrosamiento de los septos perirrenales.

4. VARICES
Pueden verse en pacientes con hipertensión portal y colaterales esplenorrenales.
5. PRESENCIA DE GAS.
Puede verse gas perirrenal en pacientes con traumatismos abiertos, antecedentes quirúrgicos o intervencionistas, abscesos, pielonefritis enfisematosa o perforación duodenal o colónica.

Bibliografía:
Patología del espacio perirrenal. Navarro Sanchís, E. et al. SERAM 2012, S-0131.
Imaging of Renal Lymphoma: Patterns of Disease with Pathologic Correlation
Bilateral extra adreanal perirenal myelolipomas: CT features.
Deja un comentario